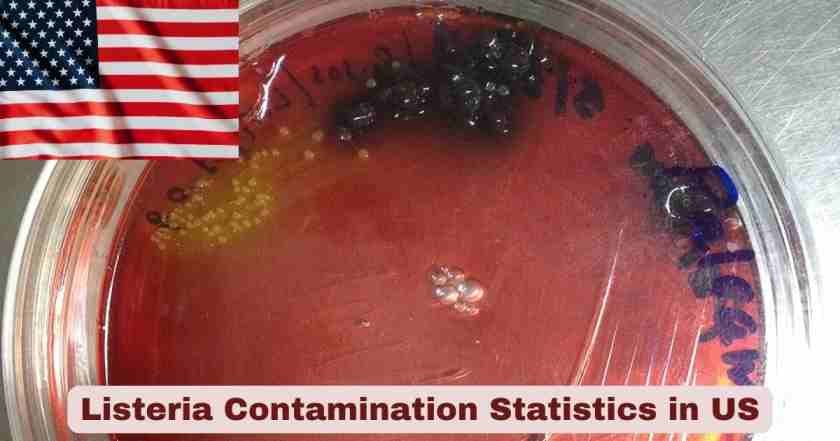
Listeria in US

Listeria Contamination in the US 2026
Listeria contamination represents one of the deadliest foodborne illnesses affecting Americans, with Listeria monocytogenes bacteria causing severe infections that result in the highest hospitalization and death rates among all common food poisoning pathogens. As of January 2026, the United States continues to grapple with multiple ongoing listeria outbreaks linked to ready-to-eat foods, with the most significant being a prepared pasta meals outbreak that has claimed six lives and sickened 27 people across 18 states since August 2024. The Centers for Disease Control and Prevention (CDC) estimates that approximately 1,600 Americans contract listeriosis annually, with a staggering 260 deaths occurring each year, translating to a case-fatality rate of approximately 16 to 20 percent—far exceeding the mortality rates of other foodborne pathogens like Salmonella or E. coli.
The severity of listeria infections in 2026 is compounded by the bacteria’s unique ability to survive and multiply in refrigerated conditions where most other pathogens cannot thrive, making contaminated refrigerated and frozen foods particularly dangerous. Unlike typical food poisoning that strikes within hours or days, listeria’s incubation period can extend from 3 days to 70 days, with a median of 11 to 27.5 days depending on the clinical manifestation and patient population, making outbreak investigations extraordinarily complex and allowing contaminated products to remain in circulation for extended periods. The 2024 and 2025 outbreaks have demonstrated the persistent contamination problems in food production facilities, with some outbreaks traced back to contamination dating to 2014 or 2018, highlighting the bacterium’s ability to establish long-term residence in food processing environments despite sanitation efforts.
Key Facts and Latest Statistics on Listeria Contamination in the US 2026
| Statistic Category | Data Point | Time Period | Source |
|---|---|---|---|
| Annual US Listeriosis Cases | 1,600 infections | Annually | CDC Estimates |
| Annual US Listeria Deaths | 260 fatalities | Annually | CDC Estimates |
| Case-Fatality Rate | 16-20% | Ongoing | CDC Data |
| Current Prepared Meals Outbreak Cases | 27 illnesses | August 2024 – October 2025 | CDC |
| Current Outbreak Deaths | 6 deaths | August 2024 – October 2025 | CDC |
| Current Outbreak Hospitalizations | 25 hospitalized (92.6%) | August 2024 – October 2025 | CDC |
| States Affected (Prepared Meals Outbreak) | 18 states | Current outbreak | CDC |
| 2024-2025 Supplement Shakes Outbreak | 42 cases, 14 deaths | August 2018 – March 2025 | CDC/FDA |
| 2024 Boar’s Head Deli Meat Outbreak | 60 cases, 10 deaths | May – November 2024 | CDC |
| 2024 Total Food Recalls Involving Listeria | 65 recalls (22% of all recalls) | 2024 | U.S. PIRG Analysis |
Data sources: Centers for Disease Control and Prevention, FDA, USDA-FSIS, U.S. PIRG Education Fund
The latest statistics on listeria contamination paint a sobering picture of America’s ongoing food safety challenges as we progress through 2026. The annual burden of approximately 1,600 listeriosis cases resulting in 260 deaths represents a case-fatality rate of 16-20%—dramatically higher than Salmonella’s 0.4% fatality rate or E. coli’s 1% rate, making listeria the third leading cause of death from foodborne illness despite causing far fewer total infections. The ongoing prepared meals outbreak that began in August 2024 has now claimed six lives and sickened 27 people across 18 states, with a hospitalization rate of 92.6% demonstrating the severe nature of these infections. The outbreak’s extended timeline—spanning over 14 months from the first illness to the most recent—illustrates listeria’s exceptionally long incubation period that complicates outbreak detection and control. The 2024-2025 supplement shakes outbreak proved even deadlier, with 14 deaths among 42 cases (a 33% fatality rate) affecting vulnerable populations in long-term care facilities across 21 states, with some illnesses traced back to August 2018, revealing nearly seven years of persistent contamination. The Boar’s Head deli meat outbreak in 2024 became one of the largest and deadliest in recent history, resulting in 10 deaths and 60 hospitalizations, ultimately forcing the permanent closure of the contaminated Virginia facility that employed 500 workers. The 65 listeria-related food recalls in 2024 represented 22% of all food recalls that year, up from 47 recalls in 2022, indicating either improved detection or worsening contamination problems industry-wide.
Listeria Symptoms and Clinical Manifestations in the US 2026
| Symptom Category | Specific Symptoms | Onset Timeline | Population Affected |
|---|---|---|---|
| Invasive Listeriosis (Non-Pregnant) | Fever, muscle aches, headache, stiff neck, confusion, loss of balance, seizures | 1-4 weeks (median 11 days) | Elderly, immunocompromised |
| Invasive Listeriosis (Pregnant Women) | Fever, fatigue, muscle aches (flu-like symptoms) | 17-67 days (median 27.5 days) | Pregnant women |
| Pregnancy Complications | Miscarriage, stillbirth, premature delivery, life-threatening newborn infection | Variable | Fetuses and newborns |
| Gastrointestinal Listeriosis | Diarrhea, nausea, vomiting, abdominal cramps | 6 hours to 6 days | General population |
| Septicemia (Blood Infection) | High fever, chills, rapid heart rate, low blood pressure | Days to weeks | High-risk individuals |
| Meningitis | Severe headache, stiff neck, photophobia, altered mental status | 1-4 weeks | Immunocompromised, elderly |
| Encephalitis | Confusion, seizures, movement disorders, coma | Variable after infection | Severe cases |
Data sources: Centers for Disease Control and Prevention, Mayo Clinic, medical literature review
The symptoms of listeria infection vary dramatically depending on the patient population and whether the infection remains localized to the gastrointestinal tract or becomes invasive, affecting the bloodstream, brain, or pregnancy. For healthy adults, listeria may cause only mild gastrointestinal symptoms including diarrhea, nausea, and abdominal cramps that appear within 6 hours to 6 days after consuming contaminated food and typically resolve without treatment. However, in high-risk populations—including pregnant women, adults 65 and older, and immunocompromised individuals—the bacteria can cause invasive listeriosis, a severe infection with a 16-20% fatality rate. Non-pregnant individuals with invasive disease typically develop symptoms 1-4 weeks after exposure (median 11 days), presenting with fever, severe headache, stiff neck, confusion, loss of balance, and seizures when the infection spreads to the nervous system causing meningitis or encephalitis. The infection can cause septicemia (blood poisoning) with high fever, chills, and potentially life-threatening complications.
Pregnant women face particularly insidious risks because they may experience only mild flu-like symptoms—fever, fatigue, and muscle aches—with an exceptionally long incubation period of 17-67 days (median 27.5 days), yet the infection can be devastating to the fetus. Listeria crosses the placenta, causing miscarriage, stillbirth, premature delivery, or severe newborn infection that can result in meningitis, sepsis, or death in infants. Pregnant women are approximately 10 times more likely to contract listeriosis than the general population, and pregnancy-associated cases account for roughly 17% of all listeriosis cases despite pregnant women representing a small fraction of the population. The extended incubation period—which can reach 70 days in some cases—makes outbreak investigation extraordinarily difficult, as patients often cannot remember what they ate two months prior, and contaminated products may have been consumed and discarded long before illness occurs. This prolonged timeline explains why the prepared meals outbreak that started with illnesses in August 2024 wasn’t identified until October 2025, allowing contaminated products to circulate for over a year.
Major Listeria Outbreaks in the US 2024-2026
| Outbreak | Cases | Deaths | Hospitalizations | States Affected | Timeline | Source |
|---|---|---|---|---|---|---|
| Prepared Pasta Meals | 27 | 6 | 25 (92.6%) | 18 states | Aug 2024 – Oct 2025 | Contaminated prepared meals |
| Supplement Shakes (Long-term Care) | 42 | 14 | All hospitalized | 21 states | Aug 2018 – Mar 2025 | Manufacturing contamination |
| Boar’s Head Deli Meats | 60 | 10 | 59 (98%) | 19 states | May – Sept 2024 | Liverwurst and deli meats |
| BrucePac Ready-to-Eat Meats | 11 confirmed | 0 | All hospitalized | 4 states | June – Oct 2024 | Pre-cooked meats |
| Yu Shang Food Tofu and Bean Products | 11 | 0 | 9 (82%) | 4 states | Sept 2023 – July 2024 | Tofu products |
| Queso Fresco and Cotija Cheese (Rizo-López) | 26 | 2 | 23 (88%) | 11 states | Jan 2014 – Dec 2023 | Mexican-style cheeses |
| Walnuts (Gibson Farms) | 12 | 2 | 10 (83%) | 6 states | Feb – May 2024 | In-shell walnuts |
Data sources: CDC Outbreak Investigation Reports, FDA Enforcement Actions, news reporting
The major listeria outbreaks between 2024 and 2026 demonstrate the persistent and widespread nature of contamination across diverse food categories. The prepared pasta meals outbreak affecting 27 people across 18 states with 6 deaths and a 92.6% hospitalization rate highlights the dangers of ready-to-eat refrigerated products. The CDC investigation revealed that 94% of interviewed patients reported consuming pasta meals from grocery stores, with the outbreak persisting for over 14 months before being publicly announced in October 2025. The supplement shakes outbreak proved even more devastating with 14 deaths among 42 cases—a 33% case-fatality rate—primarily affecting elderly residents in long-term care facilities across 21 states. Shockingly, whole genome sequencing traced some cases back to August 2018, revealing nearly seven years of continuous contamination in the manufacturing facility, raising serious questions about inspection and oversight failures.
The Boar’s Head outbreak in 2024 became one of the deadliest in recent US history, claiming 10 lives and sickening 60 people with a 98% hospitalization rate across 19 states. The outbreak led to the recall of over 7 million pounds of deli meats and the permanent closure of the Jarratt, Virginia facility where inspectors documented 69 noncompliance records including mold, mildew, dripping water, and insects throughout the plant. The BrucePac ready-to-eat meats outbreak in 2024 triggered a massive recall of nearly 10 million pounds of pre-cooked chicken products used in frozen meals, salads, and wraps distributed nationwide. The Yu Shang Food tofu outbreak affecting 11 people demonstrates that vegetarian products are not immune to contamination. The Rizo-López cheese outbreak spanning nearly 10 years from 2014 to 2023 resulted in 2 deaths and 26 illnesses, leading to a recall of over 60 brands of Mexican-style cheeses and the permanent closure of two facilities, with the extended timeline showing that contamination can persist undetected for years in food processing environments.
High-Risk Foods for Listeria Contamination in the US 2026
| Food Category | Specific High-Risk Items | Risk Level | Common Contamination Source |
|---|---|---|---|
| Deli Meats and Hot Dogs | Sliced turkey, ham, roast beef, bologna, hot dogs | Very High | Slicing equipment, post-cooking contamination |
| Soft Cheeses | Queso fresco, Brie, Camembert, blue cheese, feta | Very High | Unpasteurized milk, processing environment |
| Smoked Seafood | Lox, smoked salmon, trout, other refrigerated fish | High | Processing and packaging contamination |
| Ready-to-Eat Salads | Pre-packaged salads, coleslaw, potato salad | High | Cross-contamination during preparation |
| Prepared Meals | Pasta dishes, meat-based meals, frozen entrees | High | Manufacturing environment contamination |
| Raw Sprouts | Alfalfa, bean, clover sprouts | High | Growing conditions, seed contamination |
| Melons | Cantaloupe, honeydew, watermelon | Moderate-High | Soil contamination, rough skin |
| Ice Cream | Especially soft-serve and unpasteurized | Moderate | Equipment contamination, unpasteurized ingredients |
Data sources: CDC foodborne illness data, FDA high-risk food categories, outbreak investigation findings
The high-risk foods for listeria contamination share common characteristics that make them particularly dangerous: they are typically ready-to-eat, stored under refrigeration, and often consumed without further cooking that would kill the bacteria. Deli meats represent one of the highest-risk categories, as demonstrated by the Boar’s Head outbreak that killed 10 people in 2024. The slicing process can introduce contamination even if the original product was safe, and listeria can grow during refrigerated storage, with concentrations increasing over time. The CDC specifically warns pregnant women to avoid deli meats unless heated to 165°F until steaming hot immediately before consumption. Soft cheeses made from unpasteurized (raw) milk pose severe risks, with the Rizo-López outbreak spanning 10 years and affecting 26 people. Even pasteurized soft cheeses can become contaminated during manufacturing, and their high moisture content provides an ideal environment for bacterial growth.
Smoked seafood products like lox and smoked salmon frequently appear on outbreak lists, with refrigerated smoked fish products accounting for numerous listeria cases annually. Pre-packaged salads and prepared foods—as evidenced by the prepared pasta meals outbreak—are increasingly implicated as consumers shift toward convenient ready-to-eat options. The BrucePac recall of 10 million pounds of pre-cooked chicken in 2024 demonstrates the scale of risk in this category. Raw sprouts have been linked to multiple outbreaks because the warm, humid conditions ideal for sprouting also promote bacterial growth, and sprouts are typically eaten raw. Melons, particularly cantaloupe, have a rough, netted skin that can harbor bacteria which gets transferred to the flesh during cutting. A devastating 2011 cantaloupe outbreak killed 33 people and sickened 147, making it the deadliest foodborne illness outbreak in modern US history. Ice cream may seem unlikely, but the 2015 Blue Bell outbreak linked to three deaths forced a complete company shutdown and nationwide recall, demonstrating that even frozen products can harbor dangerous levels of listeria if contaminated before freezing.
Listeria Incubation Period and Outbreak Detection in the US 2026
| Clinical Presentation | Incubation Period Range | Median Incubation | Detection Challenges |
|---|---|---|---|
| Gastrointestinal Illness | 6 hours to 6 days | ~24 hours | Rarely reported, mild symptoms |
| Invasive Disease (Non-Pregnant) | 1 to 4 weeks | 11 days | Long delay from exposure to illness |
| Pregnancy-Associated | 17 to 67 days | 27.5 days | Extremely long delay, mild maternal symptoms |
| Septicemia | Days to 4+ weeks | Variable | Depends on bacterial load and immunity |
| Meningitis/Encephalitis | 1 to 4+ weeks | ~2-3 weeks | Severe neurological complications |
| Maximum Documented Incubation | Up to 70 days | N/A | Recall difficulty, product disposal |
| Average Outbreak Detection Time | Months to years | Several months | Limited patient interviews, WGS required |
Data sources: CDC outbreak investigation methodology, medical literature, epidemiological studies
The extended incubation period of listeria creates unprecedented challenges for public health officials attempting to identify and stop outbreaks. While most foodborne pathogens like Salmonella or E. coli cause illness within 12-72 hours, allowing patients to recall recently consumed foods, listeria’s 1-4 week incubation for invasive disease means patients develop symptoms long after disposing of product packaging and forgetting meal details. For pregnancy-associated cases, the median 27.5-day incubation (ranging 17-67 days, with some cases extending to 70 days) makes source identification nearly impossible through patient interviews alone. A pregnant woman who suffers a miscarriage in October may have consumed the contaminated food in August, with no memory of specific products eaten two months prior.
This explains why the prepared pasta meals outbreak that began with illnesses in August 2024 wasn’t identified and announced until October 2025—over 14 months later. The supplement shakes outbreak proved even more complex, with cases spanning from August 2018 to March 2025, nearly seven years, with the contamination source only identified through advanced whole genome sequencing (WGS) that matched bacterial DNA from patients to environmental samples from the manufacturing facility. Modern outbreak detection relies heavily on PulseNet, the national molecular subtyping network that uses WGS to create genetic fingerprints of listeria strains, allowing epidemiologists to identify clusters of related cases even when patients are separated by thousands of miles and months or years in time. However, this technology-dependent approach means outbreaks are only detected after multiple severe illnesses or deaths occur, products have often been consumed, and contamination may have persisted for years in production facilities, as demonstrated by the Rizo-López cheese outbreak that went undetected for nearly a decade before being linked to 26 illnesses and 2 deaths.
High-Risk Populations for Listeria Infection in the US 2026
| High-Risk Group | Increased Risk Factor | Annual Cases (Estimated) | Special Considerations |
|---|---|---|---|
| Pregnant Women | 10x higher risk | ~170 cases (17% of invasive cases) | Fetal death, miscarriage, newborn infection |
| Adults 65 Years and Older | 4x higher risk | ~800 cases (50% of invasive cases) | Higher mortality, comorbidities |
| Immunocompromised (Cancer Patients) | Significantly elevated | Part of ~800 immunocompromised cases | Chemotherapy weakens immunity |
| Organ Transplant Recipients | Significantly elevated | Part of immunocompromised total | Anti-rejection drugs suppress immunity |
| HIV/AIDS Patients | Significantly elevated | Declining proportion with modern treatment | Depends on CD4 count |
| Diabetes Patients | Moderately elevated | Unknown specific count | Immune system dysfunction |
| Kidney Disease Patients | Moderately elevated | Unknown specific count | Dialysis patients particularly vulnerable |
| Chronic Liver Disease | Moderately elevated | Unknown specific count | Impaired immune function |
Data sources: CDC listeria surveillance, medical research, epidemiological data
The high-risk populations for listeria face dramatically elevated infection rates and mortality compared to healthy adults, with pregnant women approximately 10 times more likely to contract listeriosis than non-pregnant healthy adults. Despite representing a small fraction of the population, pregnancy-associated cases account for roughly 17% of all invasive listeriosis cases, or approximately 170 of the 1,600 annual US cases. The infection can be catastrophic for fetuses and newborns even when the mother experiences only mild flu-like symptoms, with outcomes including miscarriage, stillbirth, premature delivery, or severe newborn infection that can cause meningitis, sepsis, or death. The supplement shakes outbreak affecting long-term care facilities demonstrated the vulnerability of elderly populations, with 14 deaths among 42 cases—a 33% fatality rate—highlighting how listeriosis disproportionately kills older adults. Adults 65 and older are approximately 4 times more likely than the general population to develop listeriosis and account for roughly 50% of all invasive cases, or about 800 of the 1,600 annual infections.
Immunocompromised individuals—including cancer patients undergoing chemotherapy, organ transplant recipients taking anti-rejection medications, HIV/AIDS patients with low CD4 counts, and those with autoimmune diseases taking immunosuppressant drugs—face significantly elevated risks because their weakened immune systems cannot effectively fight the bacterial invasion. These patients account for a substantial portion of the remaining 800 or so annual invasive cases not attributed to pregnancy or advanced age. Chronic disease patients with diabetes, kidney disease, or liver disease also experience elevated risk due to immune system dysfunction, though quantifying their specific risk levels proves difficult. The Boar’s Head outbreak in 2024 exemplified this vulnerability, with 59 of 60 patients (98%) requiring hospitalization and 10 deaths, far exceeding hospitalization and death rates for other foodborne pathogens. Public health agencies strongly recommend that all high-risk individuals avoid ready-to-eat deli meats, unpasteurized dairy products, smoked seafood, and other high-risk foods, or heat these products to 165°F (steaming hot) immediately before consumption to kill any listeria bacteria present.
Listeria Prevention and Food Safety Guidelines in the US 2026
| Prevention Strategy | Specific Actions | Effectiveness | Population |
|---|---|---|---|
| Cook Ready-to-Eat Foods | Heat deli meats, hot dogs to 165°F until steaming | Very High | Pregnant women, high-risk groups |
| Avoid High-Risk Foods | No soft cheeses from unpasteurized milk, no deli meats, no smoked seafood | Very High | Pregnant women, immunocompromised |
| Proper Refrigeration | Keep refrigerator at 40°F or below, freezer at 0°F or below | Moderate | All populations |
| Use-by Date Compliance | Do not consume products past use-by dates | High | All populations |
| Clean Refrigerator Regularly | Clean spills immediately, sanitize monthly with bleach solution | Moderate-High | All populations |
| Separate Foods | Keep raw meat separated from ready-to-eat foods | High | All populations |
| Wash Produce | Rinse fruits and vegetables under running water, scrub melons | Moderate | All populations |
| Hand Washing | Wash hands with soap for 20 seconds after handling raw foods | High | All populations |
Data sources: CDC prevention guidelines, FDA food safety recommendations, USDA-FSIS guidance
Prevention of listeria infection requires vigilant food safety practices, especially for high-risk populations who should implement stricter precautions than the general public. The most effective strategy for pregnant women and immunocompromised individuals is complete avoidance of high-risk foods including deli meats, soft cheeses made from unpasteurized milk, smoked seafood, and refrigerated pâtés or meat spreads. If consuming these foods, they must be heated to 165°F until steaming hot immediately before eating, which kills listeria bacteria. This is critical because listeria uniquely grows at refrigeration temperatures where most other bacteria cannot survive, meaning contaminated refrigerated foods become progressively more dangerous over time rather than safer. Hot dogs and deli meats should be reheated until steaming even if the package states “fully cooked,” as the Boar’s Head outbreak demonstrated that post-processing contamination can occur during slicing and packaging.
Refrigerator management plays a crucial role in listeria prevention. Maintaining temperatures at 40°F or below slows but does not stop listeria growth, while freezing at 0°F stops growth but doesn’t kill the bacteria—contaminated products remain dangerous when thawed. Regular refrigerator cleaning is essential because listeria can establish persistent contamination in drip pans, shelving, and door gaskets. Clean spills immediately and sanitize the entire refrigerator monthly with a solution of 1 tablespoon bleach per gallon of water, paying special attention to areas where raw meat is stored. Respecting use-by dates is critical because listeria populations increase over time; products past their dates pose higher risks. Washing produce thoroughly under running water helps remove surface contamination, though it cannot eliminate bacteria that have penetrated the food. For melons, use a clean brush to scrub the rind before cutting, as bacteria on the surface can be transferred to the flesh by the knife. Separating raw meats from ready-to-eat foods prevents cross-contamination, and thorough hand washing for 20 seconds with soap after handling raw foods eliminates bacteria transfer. These practices, while requiring diligence, can substantially reduce listeria infection risk for all populations, potentially preventing hundreds of illnesses and dozens of deaths annually.
Food Recall Patterns and Regulatory Response in the US 2026
| Recall Metric | 2024 Data | 2023 Data | 2022 Data | Trend |
|---|---|---|---|---|
| Total Listeria Recalls | 65 recalls | ~55 recalls | 47 recalls | Increasing |
| Percentage of All Food Recalls | 22% of total | ~20% | ~18% | Rising proportion |
| Pounds of Product Recalled | Tens of millions | Variable | Variable | Large-scale recalls increasing |
| Facilities Permanently Closed | 3+ facilities | Variable | Variable | Post-outbreak closures |
| Class I Recalls (Most Serious) | Majority | Majority | Majority | Serious contamination dominant |
| Deaths from Recalled Products | 30+ deaths | Variable | Variable | Deadly outbreaks continuing |
| Multi-State Outbreaks | 6+ major outbreaks | Variable | Variable | Widespread distribution problems |
Data sources: FDA Enforcement Reports, USDA-FSIS recall database, U.S. PIRG Education Fund analysis
The food recall patterns for listeria contamination in 2024 reveal an troubling upward trend, with 65 listeria-related recalls representing 22% of all food recalls that year according to U.S. PIRG Education Fund analysis. This marks a substantial increase from 47 listeria recalls in 2022, representing a 38% increase in just two years. The recalls spanned diverse product categories including deli meats, cheeses, prepared meals, seafood, produce, and frozen foods, demonstrating that contamination problems affect virtually all sectors of the food industry. Many recalls involved millions of pounds of product, with the BrucePac recall alone covering nearly 10 million pounds of ready-to-eat meat and poultry products, and the Boar’s Head recall exceeding 7 million pounds of deli meats. The Class I classification—reserved for products that could cause serious health consequences or death—applied to the vast majority of listeria recalls, reflecting the pathogen’s deadly nature.
The regulatory response to major outbreaks has included permanent facility closures following serious contamination events, with the Boar’s Head Jarratt, Virginia plant closing permanently after 69 noncompliance records documented appalling sanitary conditions including mold, mildew, insects, and structural failures that allowed contamination to persist. The facility’s closure eliminated 500 jobs but was deemed necessary after 10 deaths and 60 illnesses. Similarly, Rizo-López Foods permanently closed two facilities after the decade-long cheese contamination was finally traced to their operations. However, critics argue that regulatory agencies remain understaffed and underfunded, with USDA-FSIS and FDA unable to conduct sufficiently frequent inspections of the thousands of food processing facilities operating nationwide. The supplement shakes outbreak that persisted from 2018 to 2025 raised serious questions about inspection frequency and effectiveness, as contamination continued for seven years before being detected. Advocacy groups call for increased inspection funding, mandatory environmental testing, stricter enforcement of sanitation standards, and faster outbreak response protocols to prevent the hundreds of listeriosis deaths occurring annually in the United States.
Economic Impact of Listeria Contamination in the US 2026
| Economic Category | Estimated Cost/Impact | Affected Parties | Details |
|---|---|---|---|
| Annual Healthcare Costs | $2.8 billion | Healthcare system, patients | Treatment, hospitalization, long-term care |
| Boar’s Head Recall Cost | $100+ million estimated | Company | Product destruction, legal costs, brand damage |
| Boar’s Head Facility Closure | 500 jobs lost | Workers, community | Permanent plant shutdown |
| BrucePac Recall Cost | Tens of millions | Company and customers | 10 million pounds recalled |
| Average Wrongful Death Settlement | $1-10 million per case | Families, companies | Litigation costs |
| Company Bankruptcy | Rizo-López Foods | Owners, creditors, workers | Filed bankruptcy after outbreak |
| Sales Impact (Industry-Wide) | Hundreds of millions | Entire sector | Consumer avoidance of category |
| Lost Productivity | Significant | Employers, economy | Hospitalizations, deaths |
Data sources: Economic impact studies, company financial reports, news analysis
The economic impact of listeria contamination extends far beyond immediate healthcare costs, affecting companies, workers, communities, and the broader food industry. The annual healthcare costs associated with listeriosis in the United States are estimated at approximately $2.8 billion, covering emergency department visits, hospitalizations averaging 14 days, intensive care treatment, antibiotic therapy, and long-term care for survivors with permanent neurological damage from meningitis or encephalitis. For individual companies, a major listeria outbreak can prove catastrophic, with the Boar’s Head recall estimated to cost the company over $100 million in direct expenses including product destruction, facility sanitization, recall logistics, legal settlements, and brand rehabilitation efforts. The company’s decision to permanently close the contaminated Virginia facility eliminated 500 manufacturing jobs, devastating the local community and workers who lost their livelihoods.
The BrucePac recall of nearly 10 million pounds of ready-to-eat chicken products cost tens of millions in direct recall expenses while also affecting hundreds of downstream companies that incorporated the contaminated chicken into their frozen meals, salads, and prepared foods, forcing them to recall their own products. Rizo-López Foods filed for Chapter 11 bankruptcy protection following their cheese contamination outbreak, unable to survive the financial burden of the recall, legal liabilities, and complete loss of customer trust after 26 illnesses, 2 deaths, and a 10-year contamination timeline. Wrongful death lawsuits from listeria outbreaks routinely result in multi-million dollar settlements, with families of victims claiming negligence, inadequate sanitation, and failure to implement proper food safety protocols. The Boar’s Head outbreak has already generated numerous lawsuits that could ultimately cost the company tens or hundreds of millions in legal settlements and judgments. Beyond individual companies, entire product categories experience sales declines following major outbreaks as consumers avoid deli meats, soft cheeses, or other implicated foods industry-wide, costing innocent companies hundreds of millions in lost revenue despite having no connection to the contamination.
Listeria Testing and Detection Methods in the US 2026
| Testing Method | Application | Timeframe | Accuracy | Use Case |
|---|---|---|---|---|
| Traditional Culture Method | Confirms listeria presence | 24-72 hours | Very High (Gold Standard) | Regulatory standard |
| Whole Genome Sequencing (WGS) | Identifies specific strain, links cases | 1-2 days after culture | Extremely High | Outbreak investigation |
| PCR (Polymerase Chain Reaction) | Rapid detection of listeria DNA | 2-24 hours | High | Preliminary screening |
| ELISA (Enzyme-Linked Immunosorbent Assay) | Detects listeria antigens | 12-48 hours | Moderate-High | Rapid screening |
| ATP Bioluminescence | Detects overall contamination | Minutes | Low specificity | Sanitation verification |
| Environmental Swabbing | Finds contamination in facilities | Varies | High when targeted properly | Prevention, investigation |
| Blood Culture (Clinical) | Diagnoses patient infection | 24-72 hours | High for invasive disease | Patient diagnosis |
Data sources: FDA testing guidelines, CDC laboratory methods, food safety research
Listeria testing and detection has evolved dramatically with the implementation of Whole Genome Sequencing (WGS) technology, revolutionizing outbreak investigation and source identification. The traditional culture method remains the gold standard for confirming listeria presence, requiring 24-72 hours to grow bacterial colonies from food, environmental, or clinical samples. Once cultured, samples undergo WGS analysis that creates a genetic fingerprint of the specific bacterial strain, allowing epidemiologists to determine whether cases in different states and different time periods stem from the same contamination source. This technology enabled investigators to link the supplement shakes outbreak spanning from 2018 to 2025 to a single manufacturing facility, and connected 27 illnesses across 18 states in the prepared meals outbreak despite the extended timeline and geographic distribution. The PulseNet database maintains genetic sequences from thousands of listeria samples, allowing real-time comparison when new cases are identified.
PCR testing provides more rapid results within 2-24 hours by detecting listeria DNA directly without waiting for bacterial growth, making it valuable for preliminary screening of food products before they leave manufacturing facilities. However, PCR cannot differentiate between live and dead bacteria, potentially flagging products that underwent adequate heat treatment but still contain bacterial DNA from killed organisms. Environmental swabbing programs in food processing facilities test surfaces, equipment, drains, and floors for listeria contamination, allowing companies to identify and eliminate harborage sites where bacteria establish persistent colonies. The Boar’s Head investigation revealed that the plant had failed to implement adequate environmental monitoring, allowing contamination to persist across multiple production areas. Clinical diagnosis of invasive listeriosis requires blood or cerebrospinal fluid cultures.
Disclaimer: This research report is compiled from publicly available sources. While reasonable efforts have been made to ensure accuracy, no representation or warranty, express or implied, is given as to the completeness or reliability of the information. We accept no liability for any errors, omissions, losses, or damages of any kind arising from the use of this report.